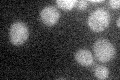
YIL037C
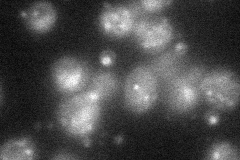
YIL037C
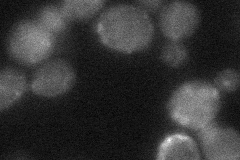
YIL037C

View description
Pheromone-regulated protein, predicted to have 4 transmembrane segments and a coiled coil domain; regulated by Ste12p; required for efficient nuclear fusion
Localization:
Intensity:
Fold change:
Significance:
-
C’ GFP library in SD
below threshold15.6 -
N' NOP1pr-GFP in SD
punctate,bud neck41.7344 -
N' TEF2pr-mCherry in SD

cell periphery,vacuole86.9204 -
N' NATIVEpr-GFP in SD

below threshold13.7716 -
N' TEF2pr-VC and Cyto-VN in SD
cytosol,punctate29.4565 -
C’ GFP library in SD+DTT

cytosol13.840.88No -
C’ GFP library in SD+H2O2

cytosol14.580.93No -
C’ GFP library in Starvation Media

cytosol17.321.11No -
C’ GFP library on the background of Pup2-DaMP

below threshold -
C’ GFP library on the background of CCT mutant

below threshold15.34770.98328No
